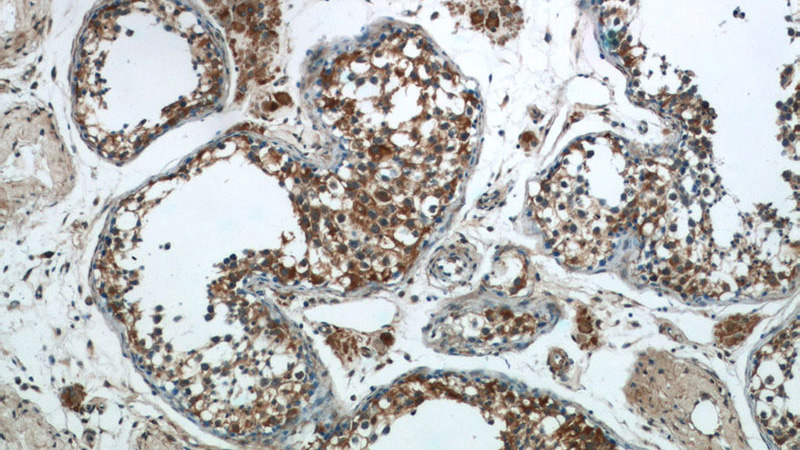
Immunohistochemistry of paraffin-embedded human testis tissue slide using Catalog No:114338(PUMA Antibody) at dilution of 1:200 (under 10x lens)
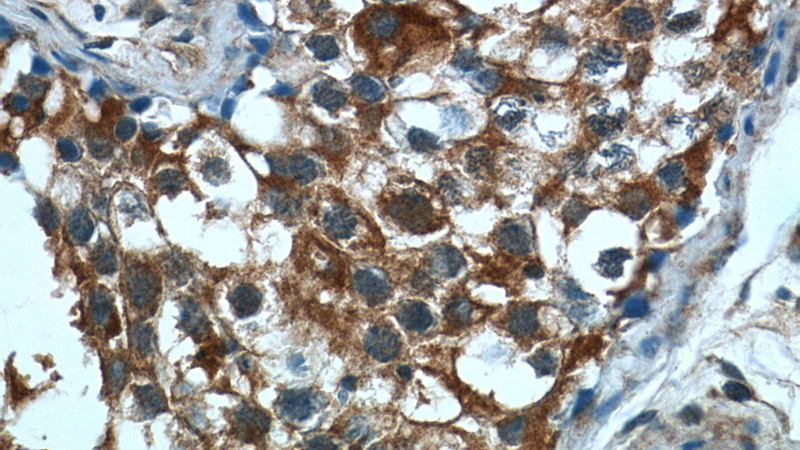
Immunohistochemistry of paraffin-embedded human testis tissue slide using Catalog No:114338(PUMA Antibody) at dilution of 1:200 (under 40x lens)

-
Product Name
PUMA antibody
- Documents
-
Description
PUMA Rabbit Polyclonal antibody. Positive WB detected in A549 cells, HepG2 cells. Positive IP detected in mouse heart tissue. Positive IHC detected in human testis tissue. Observed molecular weight by Western-blot: 18-21 kDa
-
Tested applications
ELISA, WB, IP, IHC
-
Species reactivity
Human,Mouse,Rat; other species not tested.
-
Alternative names
BBC3 antibody; JFY 1 antibody; JFY1 antibody; PUMA antibody
-
Isotype
Rabbit IgG
-
Preparation
This antibody was obtained by immunization of Peptide (Accession Number: NM_014417). Purification method: Antigen affinity purified.
-
Clonality
Polyclonal
-
Formulation
0.1M NaHCO3, 0.1M glycine, 0.02% sodium azide and 50% glycerol pH 7.3.
-
Storage instructions
Store at -20℃. DO NOT ALIQUOT
-
Applications
Recommended Dilution:
WB: 1:500-1:5000
IP: 1:200-1:2000
IHC: 1:20-1:200
-
Validations

A549 cells were subjected to SDS PAGE followed by western blot with Catalog No:114338(PUMA antibody) at dilution of 1:500

IP Result of anti-PUMA (IP:Catalog No:114338, 4ug; Detection:Catalog No:114338 1:500) with mouse heart tissue lysate 3200ug.
Immunohistochemistry of paraffin-embedded human testis tissue slide using Catalog No:114338(PUMA Antibody) at dilution of 1:200 (under 10x lens)
Immunohistochemistry of paraffin-embedded human testis tissue slide using Catalog No:114338(PUMA Antibody) at dilution of 1:200 (under 40x lens)
-
Background
PUMA, also named as JFY-1 and BBC3, belongs to the Bcl-2 family. It is a critical mediator of p53-dependent and -independent apoptosis induced by a wide variety of stimuli. It serves as a proximal signaling molecule whose expression is regulated by transcription factors in response to these stimuli. PUMA transduces death signals primarily to the mitochondria, where it acts indirectly on the Bcl-2 family members Bax and/or Bak by relieving the inhibition imposed by antiapoptotic members. It directly binds and antagonizes all known antiapoptotic Bcl-2 family members to induce mitochondrial dysfunction and caspase activation. PUMA ablation or inhibition leads to apoptosis deficiency underlying increased risks for cancer development and therapeutic resistance. It is a general sensor of cell death stimuli and a promising drug target for cancer therapy and tissue damage. It is essential mediator of p53-dependent and p53-independent apoptosis. (PMID: 19641508 )The antibody is specific to PUMA.
-
References
- Liu CJ, Zhang XL, Luo DY. Exogenous p53 upregulated modulator of apoptosis (PUMA) decreases growth of lung cancer A549 cells. Asian Pacific journal of cancer prevention : APJCP. 16(2):741-6. 2015.
- Li H, Liu Q, Wang Z. The oncoprotein HBXIP modulates the feedback loop of MDM2/p53 to enhance the growth of breast cancer. The Journal of biological chemistry. 290(37):22649-61. 2015.
Related Products / Services
Please note: All products are "FOR RESEARCH USE ONLY AND ARE NOT INTENDED FOR DIAGNOSTIC OR THERAPEUTIC USE"
